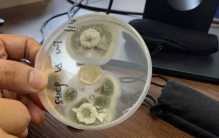
阿根廷出现超级真菌案例 致死率超过一半（超级病毒）

世界上三大巨毒蛇,从1~3分别是细鳞太攀蛇,黑曼巴蛇,巴布亚太攀蛇。在说蛇类之中最毒的蛇一直以来都有着较大的争议。毕竟每一条蛇在不同环境以及不同的状态之下,能够造成的死亡能力也是会有所不同的、排毒量、体 ...
2023-1-19 18:31

世界上最大的黄土地貌则是黄土高原。中国黄土高原则是世界上最大的黄土地貌。同时也是黄土覆盖面积最大的一个地区,有着世界上最大的黄土沉积区。位置则是在中国的中部偏北位置,总面积达到40万平方千米。 最大的黄 ...
2023-1-19 18:31

世界上最小的乌贼叫细乌贼,最大的乌贼叫大乌贼。乌贼是海洋之中的一种生物,有一些乌贼的体型特别大,但也有一些物质的体型是极其小的,特别的罕见。尤其是细乌贼,身长也就一厘米,像是指甲盖一般的大小,特别的少 ...
2023-1-19 18:31

世界上含沙量最大的河流,则是黄河起源于青藏高原。黄河不光是中国的母亲河,也是世界上含沙量最大的一条河流,同样是中国第二长河,世界第五长河。每年都能够从黄土高原地区携带出来16亿吨的泥沙。形容黄河就有着一 ...
2023-1-19 18:31

心脏移植手术的成功率大概在10%。在去年年底武汉的一个医院里面进行了一场让人惊心动魄的生命接力,来自于全国各地的三个孩子都需要在武汉的某家医院里面做自己心脏移植的手术。医生们在经过了大概十个小时的努力拼 ...
2023-1-19 18:29

动物对人类也有感情和灵性。在去年9月份,安徽就出现了一件让人们惊讶的事情。当地的一个养牛的农民,计划法在自己家养了很多年的一头牛给卖掉。结果当付了钱这个牛被牵走的时候,就出现了让人惊讶的一幕。对着自己 ...
2023-1-19 18:29

克隆生物无法保存记忆。在2022年的9月份网络上出现一个新闻,就是北京的一个女子非常思念自己家里已经去世的小狗。所以他就找到了一个克隆机构,希望能够把自己的小狗给克隆出来,据说为了能够完成自这个愿望,看花 ...
2023-1-19 18:29

白狐报恩的视频可能是摆拍。在去年的12月份,黑龙江一个男子就在网络上放出来了一段视频。通过视频我们可以是看到在一个雪地里面有一个银白色的狐狸,然后这个狐狸的一只脚下面踩着一颗灵芝。然后这个男子说你把这个 ...
2023-1-19 18:29

乌鸦和灾难之间没有直接联系。在我们中国人的观念当中,一直都认为乌鸦是一种不太吉祥的生物。平时要是看到乌鸦的话,可能很多人都会把他们给赶走,可是在去年的10月份,湖南某个地方的网友就看到了在他们城市的上空 ...
2023-1-19 18:29

机器人对着镜子笑的操作是人类下的命令。我们伟大的科学家霍金在世的时候,曾经多次告诉过人类,千万不要过度的发展人工智能要不然人类可能到最后会被毁灭。不过很显然,人类并没有听从霍金的建议,反而是大力的发展 ...
2023-1-19 18:29

机器人拥有独立意识可能会反抗人类。在前段时间,哥伦比亚的一个研究团队就提出了一个让人惊讶的想法。他们计划在人工智能当中注入一些自主意识,也就是说让机器人也有能够独立思考问题的能力。这个想法在被提出来之 ...
2023-1-19 18:29
超级真菌只在身体虚弱的人身上产生。在去年的后半年,马上快过年了,国家终于宣布我们中国的疫情开始全面放开。这也标志着我们三年的疫情抗战终于是结束了,本来大家刚刚送了一口气,结果就传出来了一个消息,阿根廷 ...
2023-1-19 18:29

月牙太阳和地月运动有直接关系。太阳是我们人类赖以生存的一个星球,不过太阳有的时候也想要休息一下。大家在前几年应该都经历过日食的现象。在2022年的10月25号的下午2点左右,广东一些地区人们就发现天黑了一些。 ...
2023-1-19 18:29

携带活体蚂蚁相当于给中国投毒。在去年的8月份,上海的海关公布工作人员在对于入境产品进行检查的时候居然发现了。一个玩具的快件当中有着接近3000只活体蚂蚁。在经过相关的生物专家鉴别之后,发现这些蚂蚁并不是普 ...
2023-1-19 18:28

癌症疫苗的价格在三万人民币左右。要是说现在人类有什么病治不了一定会有非常多的人会说癌症。在我国每年都会有很多人死于癌症,最让人们无法理解的就是不知道癌症的细胞是怎么来的。在治疗癌症的时候,很多家庭都是 ...
2023-1-19 18:28

科学家认为旅行者1号被困,极有可能是因为柯伊伯带的存在。旅行者1号为人们传回了大量有价值的照片,可是一直以来却没有飞出太阳系,被认为有一种神奇的力量阻止了它。 旅行者1号 旅行者1号自发射升空以后,就开始 ...
2023-1-19 18:28

未婚未育不在选拔的条件之内。现在我国已经成为了整个世界上航天的第一梯队,为了能够在未来有更多的航天力量,也是在前一段时间正式开始了对于航天员的选拔,大家也都知道。自从前几年开始,我国的宇航员队伍当中多 ...
2023-1-19 18:28

科学家在火星钻孔取样的储样管是空的,他们认为极有可能是封装的时候出现了问题。科学家一直没有放弃对火星的研究,他们从火星土壤入手,试图找到火星存在生命的依据。现在钻孔之后并没有取到土壤,总结了失败原因之 ...
2023-1-19 18:28

隐翅虫身体里的毒液可能导致人类皮肤坏死。每次到了夏天都会出现很多的小飞虫,人类在面对这些小飞虫的时候,都会比较习惯性的把这些消费虫给一下子拍死。大多数时候拍摄结构非常并没有什么隐响,可是在去年九月份, ...
2023-1-19 18:28

太阳系曾经存在三个文明,后来因为发生了战争而被摧毁。行星在战争中都被破坏了,原有的活力已经不复存在,地球也不可避免的受到了牵连。至少从目前已经得到的信息来看,木星和火星的小行星带也是之后才形成的。 太 ...
2023-1-19 18:28